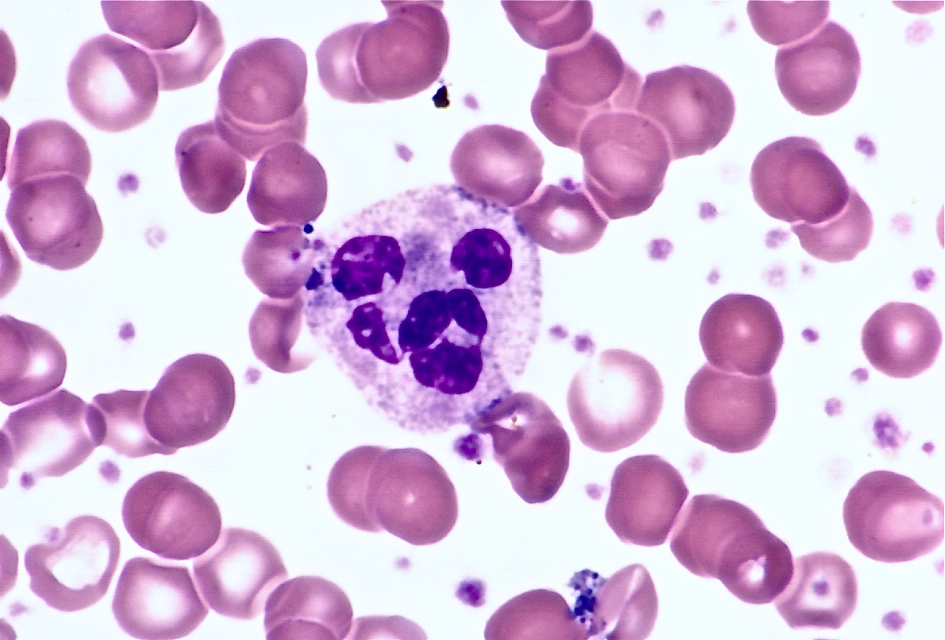
<p>The red blood cells here are representative of an anemia that is…</p>
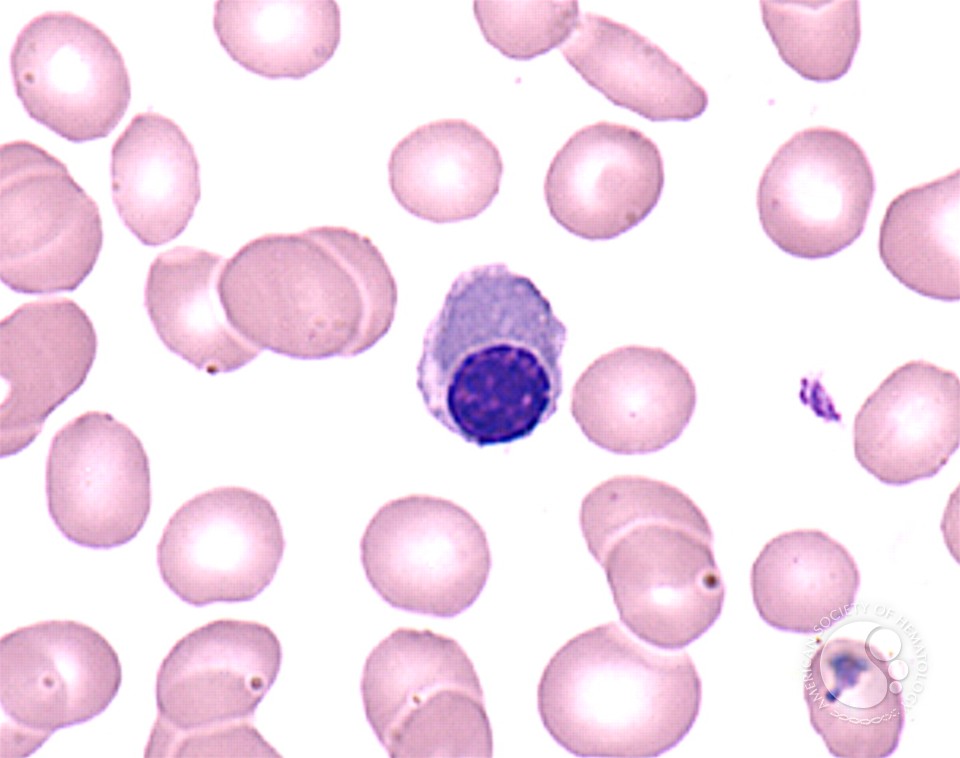
<p>The sight of this cell in a newborn most likely indicates…</p>

1/67
Looks like no tags are added yet.
Name | Mastery | Learn | Test | Matching | Spaced |
|---|
No study sessions yet.
The characteristic erythrocyte found in pernicious anemia is…
macrocytes.
Hemolysis in paroxysmal nocturnal hemoglobinuria (PNH) is…
caused by a red cell membrane defect.
What is most closely associated with idiopathic hemochromatosis?
Iron overload in tissue.
A patient with polycythemia vera who is treated by phlebotomy is most likely to develop a deficiency of…
iron.
The direct antiglobulin test can help distinguish…
between inherited and acquired spherocytosis.
Anemia of chronic inflammation is characterised by….
decreased serum iron levels.
Iron is trapped in the macrophages, making it unavailable.
Factors commonly involved in causing anemia with chronic renal disease include…
inadequate erythropoiesis due to decreased erythropoietin production.
A patient with sickle cell anemia presents with fever, increased weakness and malaise, as well as low hemoglobin and low reticulocyte count. What is the most likely explanation for her symptoms?
Aplastic crisis.
The hypoproliferative red cell population in the bone marrow of uremic patients is caused by…
decreased levels of erythropoietin.
What do these disorders have in common?
Hereditary spherocytosis
Hereditary elliptocytosis
Hereditary stomatocytosis
Paroxysmal nocturnal hemoglobinuria
Red cell membrane defects.
A geriatric patient is presents to the hospital with a chronic UTI and proteinuria. The following lab results are obtained:
WBC: 10.0 × 103 per microlitre
RBC: 3.1 × 106 per microlitre
HGB: 7.2 g/dL
HCT: 24%
MCV: 78 fL
MCH: 23 pg
MCHC: 31%
Serum iron: 29 microgram/dL
TIBC: 160 microgram/dL
Serrum ferritin: 100 ng/mL
These data are most consistent with…
anemia of chronic inflammation.
A patient with a history of chronic bleeding due to peptic ulcers is admitted, presenting with severe microcytic hypochromic anemia. What results can we expect regarding serum iron, TIBC, and storage iron?
Serum iron: decreased
TIBC: increased
Storage iron: decreased
This is consistent with iron deficiency anemia.
What is the most common cause of iron deficiency anemia?
Chronic blood loss, often due to gastrointestinal bleeding.
Evidence indicates that the genetic defect in thalassemia usually results in…
decreased globin chain production due to a quantitative deficiency of RNA.
A 20 year old African American male patient presents with symptoms indicative of thalassemia minor. The quantitative HbA2 level is normal, but the HbF level is high. What kind of thalassemia are these data most consistent with?
Delta-beta thalassemia minor.
What laboratory findings are consistent with hemolytic anemia?
Elevated bilirubin (unconjugated)
Decreased haptoglobin
Increased LDH
Elevated reticulocyte count
Deficiency of this enzyme is associated with hemolytic anemia after administration of oxidative drugs. It is also characterised by red cell inclusions formed by denatured hemoglobin.
G6PD.
Heinz bodies are common inclusions found in G6PD deficiency.
What situations can lead to hemolytic anemia in patients with G6PD deficiency?
Administration of oxidative drugs (e.g antimalarial drugs)
Infection
Ingestion of fava beans
A patient with nonspherocytic hemolytic anemia experiences a hemolytic episode after being administered anti-malarial drugs. What condition can cause this?
G6PD deficiency.
Peripheral blood smears from patients with untreated pernicious anemia are characterised by…
macrocytosis and pancytopenia.
What feature is characteristic of autoimmune hemolytic anemia?
A positive DAT test.
Lab tests performed on a patient indicate macrocytosis and pancytopenia. What disorder is most likely?
B12 deficiency
Folate deficiency
A patient presents with the following results:
RBC: 2.35 × 106 per microlitre
WBC: 3.0 × 103 per microlitre
PLT: 95 × 103 per microlitre
HGB: 9.5 g/dL
HCT: 27%
MCV: 115 fL
MCHC: 35%
MCH: 40 pg
What further tests should be done?
B12 and folate tests.
High MCV indicates macrocytosis, and the low RBC count indicates anemia.
The characteristic morphological feature in folic acid deficiency is…
macrocytosis.
A 50 year old patient is found to have the following lab results:
RBC: 2.0 × 106 per microlitre
HGB: 7.0 g/dL
HCT: 20%
It is determined the patient is suffering from pernicious anemia. Given this information, what can be expected of the WBC, PLT, and reticulocyte count?
WBC, PLT, and reticulocyte count will be low.
Pernicious anemia often leads to pancytopenia.
Megaloblastic asynchronous development in the bone marrow indicates…
impaired DNA synthesis due to low vitamin B12.
In anemia of chronic inflammation, what can we expect of the following parameters:
Serum iron
Transferrin saturation
TIBC
Serum iron: decreased
Transferrin saturation: decreased
TIBC: normal or decreased
Characteristic morphological features in hemoglobin C disease include…
target cells and rod/hexagonal inclusions (hemoglobin C crystals).
Thalassemias are characterised by…
decreased rate of globin synthesis
A patient has the laboratory results shown below:
RBC: 6.5 × 106 per microlitre
HGB: 13 g/dL
HCT: 39%
MCV: 65 micrometres3
MCH: 21.5 pg
MCHC: 33%
These results are compatible with…
Thalassemia minor.
What kind of polycythemia is a severely burned patient most likely to have?
Relative polycythemia associated with dehydration.
Laboratory findings in hereditary spherocytosis include…
decreased RBC band 3 protein.
The characteristic morphological feature in lead poisoning is…
basophilic stippling.
The white cell feature most characteristic of pernicious anemia is…
hypersegmented neutrophils.
What parameter is most consistently abnormal in hereditary spherocytosis?
MCHC.
What protein is commonly defective in hereditary elliptocytosis?
Spectrin.
What is the most common mechanism resulting in hereditary stomatocytosis?
Abnormal Na/K permeability.
The basic mechanism associated with the development of sideroblastic anemia is…
iron accumulation due to an enzymatic defect in heme synthesis.
Individuals with Fanconi anemia characteristically show…
increased HbF
hyperpigmentation
microcephaly
short stature
What tumor is associated with erythocytosis due to excessive erythropoietin production?
Renal cell carcinoma.
What feature of G6PD deficiency is typically visible on a Wright-Giemsa stain?
Bite cells.
Heinz bodies are visible when a supravital stain is applied.
What abnormal RBC morphology is associated with pyruvate kinase deficiency?
Echinocytes.
What hemoglobinopathy is associated with rod shaped crystals?
Hemoglobin C
In electrophoresis, which hemoglobin will HbD and HbG be in the same position as?
HbS
The hemoglobinopathy resulting from a fusion product of the delta and beta gene is called…
HbLepore
What would the RBC count be in a patient diagnosed with heterozygous beta thalassemia?
Elevated RBC count.
Hereditary persistence of fetal hemoglobin is due to a loss of expression of the…
gamma globin chains.
What is the specificity of cold agglutinin disease?
anti-I.
What population is most likely to present with paroxysmal cold hemoglobinuria?
Children, after a viral illness
What is the most common cause of anemia in hospitalised patients?
Anemia of chronic inflammation.
If a patient has an increased red cell mass and low EPO levels, what other test can we add on to confirm a diagnosis of polycythemia vera?
JAK2 V617F mutation.
The sight of hypersegmented neutrophils can precede what kind of changes to the MCV, MCH, and RDW?
Increase in MCV, MCH, and RDW.
This is characteristic of megaloblastic anemia.
The red blood cells here are representative of an anemia that is…
nonmegaloblastic anemia.
Megaloblastic anemia would have ovalocytes and elliptocytes.
The sight of this cell in a newborn most likely indicates…
HDN due to ABO incompatibility.
Hemoglobin H disease results from the absence of how many alpha genes?
3 out of 4 alpha genes result in Hemoglobin H disease.
The M:E ratio in polycythemia vera is usually…
Generally normal.
4:1 ratio.
In an uncomplicated case of severe iron deficiency anemia, what can be expected of the following values?
Serum iron
Serum TIBC
% saturation
Marrow % sideroblasts
Marrow iron stores
Serum ferritin
HbA2
Serum iron: Decreased
Serum TIBC: Increased
% saturation: Decreased
Marrow % sideroblasts: Decreased
Marrow iron stores: Decreased
Serum ferritin: Decreased
HbA2: Decreased
A patient has a tumor that concentrates erythropoietin. What kind of polycythemia is he most likely to have?
Polycythemia associated with renal disease.
What kind of polycythemia is often associated with lung disease?
Polycythemia secondary to hypoxia
A patient being treated for a malignant tumor for several years, and he presents with the following on his blood smear:
Oval macrocytes
Howell-Jolly bodies
Hypersegmented neutrophils
Large agranular platelets
What is the most probably cause of this presentation?
Chemotherapy.
How does the bone marrow respond to anemic stress?
Increase the production of RBCs, and some might be released prematurely.
What food can cause lethargy, abdominal pain, and hemoglobinuria in some patients with G6PD deficiency?
Fava beans.
The most likely cause of macrocytosis in primary myelofibrosis is…
Folate deficiency.
Giant, vacuolated, multinucleated erythroid precursors are present in…
erythroleukemia.
What is a significant feature of dyserythropoiesis?
Megaloblastoid erythropoiesis.
The M:E ratio in erythroleukemia is usually…
normal.
Autoimmune hemolytic anemia is often a complication of…
chronic lymphocytic leukemia.